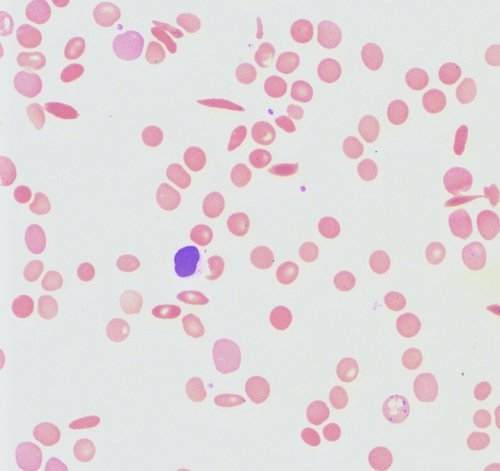
RDW (red blood cell distribution width linked with peripheral smear).image

What is RDW in a blood test?
RDW stands for Red Cell Distribution Width. It is included in the complete blood count test as it measures the variation in size and volume of red blood cells.
The regular size of RBC is six to eight cubic millimetre in diameter. Some disorders cause changes in the volume of the cells. Hence, it is not just enough to check the size of the cells but as well as the volume.
There are various instruments used to measure the RBC distribution width. If it is reported as coefficient of variation, the test is called RDW-CV. If it is reported as standard deviation, the test is called RDW-SD. (1)
Standard level of RDW and what it means in a blood test
Red blood cells distribution width’s normal value is between 10.2% and 14.5%. However, the value varies depending on the age of the patient and the equipment used in the blood test. Based on the normal values, you can see if the patient’s RDW is high or low.
If the RDW is high, it means that the red blood cells vary in sizes. There are a lot of reasons for this and to come up with a clear answer, an MCV or mean corpuscular volume should be obtained.
RDW and MCV are closely related, especially in diagnosing various blood disorders. (1, 2)

Image 1 : A blood is withdrawn from the left brachial artery to test for complete blood count
Photo Source : img-aws.ehowcdn.com
Picture Source RDW (red blood cell distribution width linked with peripheral smear)
Picture Source RDW (red blood cell distribution width linked with peripheral smear)
Photo Source : p5759554.vo.llnwd.net
What does it mean when your RDW is high?
- High RDW and high MCV – When the RDW and MCV both turned out higher than the usual, it could indicate a liver disease. The liver is the filter system of the body. It filters harmful chemicals and at the same time plays a major role in flushing out toxins from the body. A liver disease means that the liver can no longer thoroughly filter the toxins. Toxins in the blood can affect the size of RBCs. Aside from liver disease, an increased in RDW and MCV can be linked with haemolytic anemia (early red blood cell destruction). Vitamin B12 deficiency can lead to high level of RDW. (3)
- High RDW and low MCV – This could indicate a deficiency in iron leading to iron deficiency anemia. This condition causes a low level of haemoglobin in the blood. Haemoglobin plays a major role in the transport of oxygen to the cells. Not having sufficient supply of iron in the blood leads to low haemoglobin level. If this goes on for a long period of time, it could lead to anemia and other serious conditions such as thalassemia intermedia. (4)
- High RDW and normal MCV – If the result of the test revealed that the RDW is high while the MCV level is normal, this indicates that the supply of vitamin B12 in the body is not sufficient. It could also be a warning sign that your body is deficient of iron. If not address right away, it could lead to iron deficiency anemia. (4)
Causes of low RDW in a blood test?
Low RDW causes vary. The level of RDW is low if the reading showed below 10.2 %.
It could be associated with various medical disorders, but the most common one is macrocytic anemia. It is a type of blood disease wherein the number of red blood cells is not enough to supplement the needs of the body.
On top of that, the red blood cells present in the body are large. Low RDW can also be linked with microcytic anemia. In this condition, the red blood cells are abnormally small. The variation in size causes the red blood cell distribution width to be low. (5)
Other medical conditions that could result to low RDW include:
- Iron deficiency anemia secondary to poor absorption of iron and severe blood loss
- Rheumatoid arthritis
- Vitamin B6 deficiency
- Chronic anemia
- hemoglobin E trait (abnormal form of haemoglobin E)
- heterozygous thalassemia (6)
The typical low RDW symptoms include shortness of breath, diarrhea, weak muscles, glossitis (swelling of the tongue), severe paleness of the skin, nausea, rapid heart rate, loss of appetite, which could lead to weight loss.
What is the significant clinical applications of RDW in a blood test?
It is important to find out the red blood cell distribution width because it plays a major role in diagnosing a disease. These include the following:
- The level of RDW helps in checking nutritional deficiencies. A high level of RDW could indicate that your body is deficient of iron, folate, and vitamin B12.
- The RDW level is used in differentiating iron deficiency anemia from thalassaemia. The RDW of people with thalassaemia is within normal limits while in patients with anemia, the RDW is high. To accurate diagnose the disease, additional tests should be conducted.
- RDW is also useful in determining the prognosis of people with heart failure and cardiovascular disease. If the RDW is high, the prognosis is poor in patients with cardiovascular disease, especially those with myocardial infarction. The risk of death is high. (7, 8)
What to keep in mind?
RDW (Red Blood Cell Distribution Width) is a way to measure the volume and size of red blood cells. A larger than normal RBCs could indicate that there is something wrong in the body.
The normal range for RDW-SD is 29-46 fL and 11.6% for adults in RDW-CV. You have to keep in mind that just because the RDW reading is normal, it does not necessarily mean that all is well.
A normal RDW and MCV reading could indicate that you are suffering from chronic anemia, acute blood loss, or renal disease. Hence, RDW should always be checked along with other blood components.
That is the reason why it is included in the routine complete blood count test. (9, 10)
References:
- https://en.wikipedia.org
- emedicine.medscape.com
- www.ncbi.nlm.nih.gov
- www.medfriendly.com
- www.labce.com
- www.eclinpath.com
- www.livestrong.com
- www.quora.com
- www.reference.com
- https://labtestsonline.org
